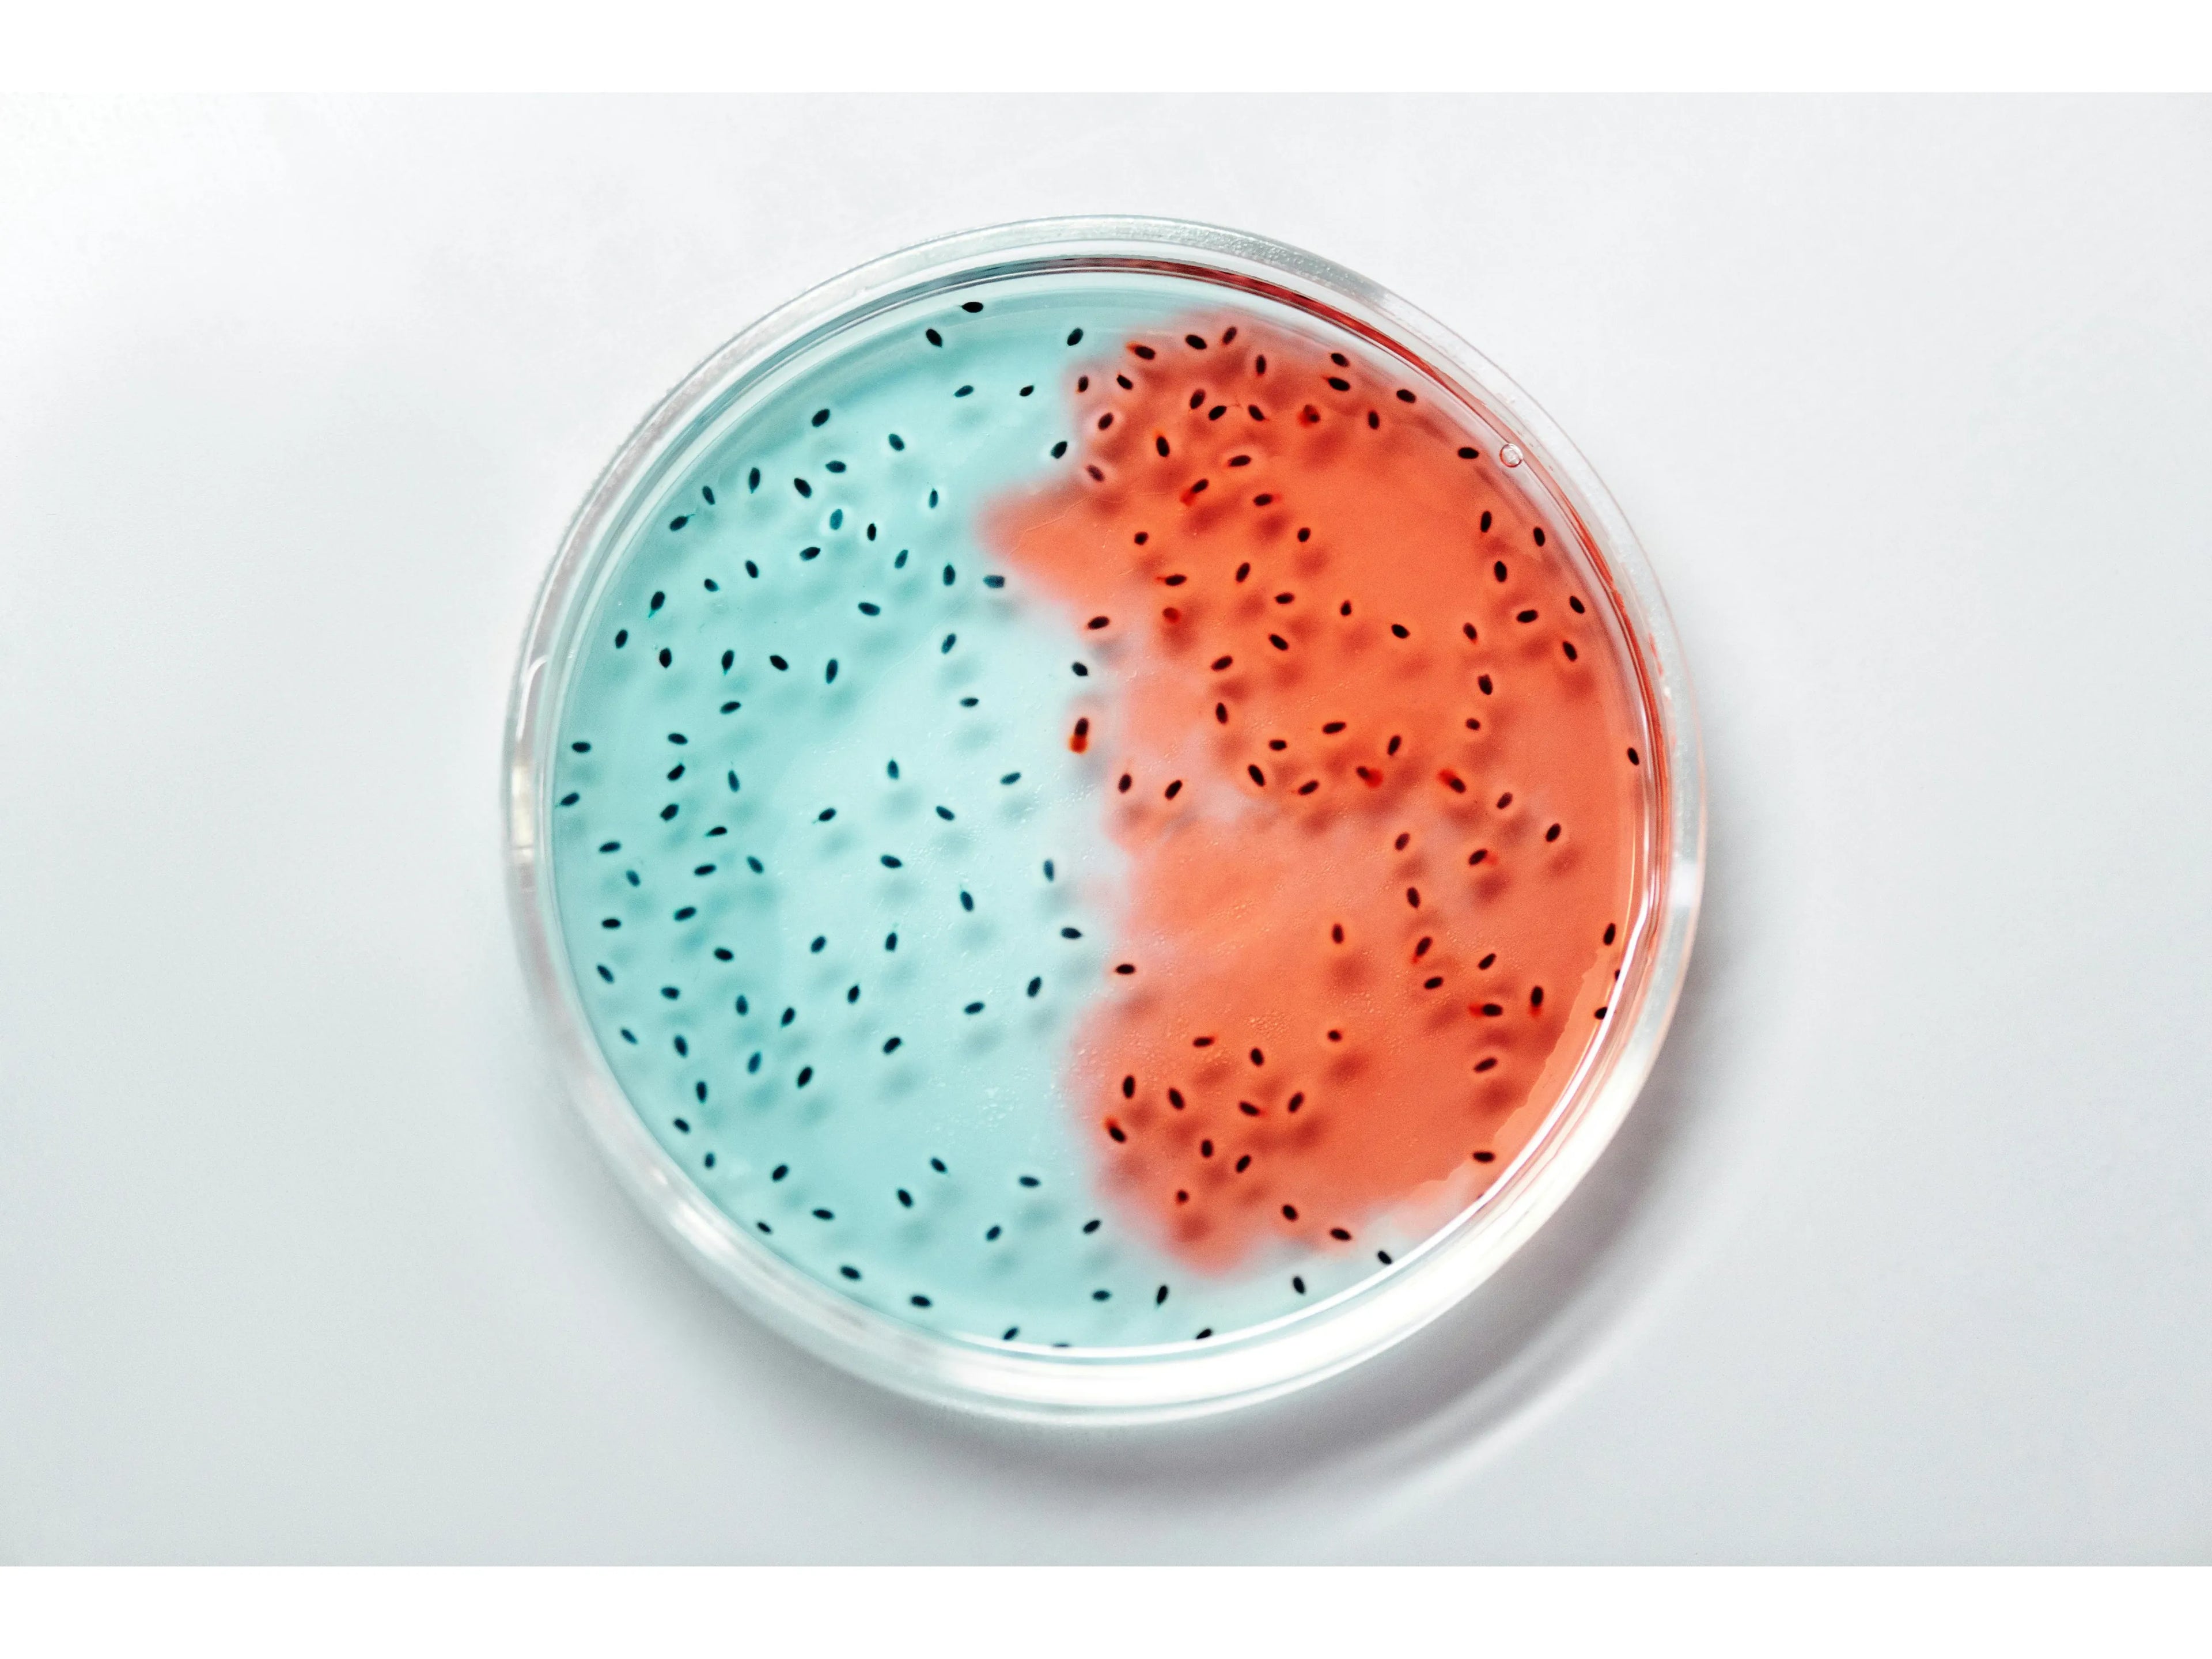

I Microrganismi
Il Mondo Invisibile dei Microrganismi Effettivi
Immagina degli esseri viventi piccolissimi, così piccoli che non possiamo vederli a occhio nudo. Sono ovunque: nell'aria, nell'acqua, nel suolo e persino dentro di noi. Anche se non li vediamo, senza di loro la vita sulla Terra non potrebbe esistere!

Da quando esistono sulla Terra e da dove vengono?
I microrganismi sono tra le prime forme di vita comparse sulla Terra, più di 3,5 miliardi di anni fa, molto prima di qualsiasi forma di vita complessa. Sono presenti in ogni angolo del pianeta, dalle profondità degli oceani alle vette delle montagne, dal suolo più fertile al deserto più arido, dal calore della lava dei vulcani al freddo siderale dei ghiacciai.
Sono nati negli oceani primordiali e, nel corso del tempo, si sono adattati a ogni ambiente possibile:
Nei mari e negli oceani, dove hanno contribuito alla formazione dell'atmosfera ricca di ossigeno
Nel suolo, dove aiutano le piante a crescere e a rigenerare la terra.
Nell'aria, trasportati dal vento e dalla pioggia.
Nel nostro corpo, dove vivono miliardi di microrganismi che ci aiutano a stare in salute.

Cosa distingue i Microrganismi Effettivi (EM)?
Mentre tutti i microrganismi svolgono funzioni importanti, i Microrganismi Effettivi (EM) sono una combinazione specifica e bilanciata di ceppi benefici selezionati per la loro capacità sinergica di promuovere la rigenerazione e la vitalità. A differenza dei microrganismi generici, gli EM nei nostri prodotti sono stati accuratamente selezionati e coltivati per massimizzare i loro effetti benefici.
Gli EM hanno la capacità di contrastare gli squilibri causati da microrganismi patogeni attraverso diversi meccanismi:
- Competizione per lo spazio e le risorse:
occupano nicchie ecologiche impedendo ai patogeni di proliferare. - Produzione di sostanze antimicrobiche che inibiscono la crescita di microrganismi dannosi.
- Modificazione del pH ambientale creando condizioni sfavorevoli per i patogeni.
- Stimolazione dei processi rigenerativi naturali dell'ambiente o dell'organismo.
Dove c'è putrefazione, cattivi odori, muffa, ruggine o malattie, l'applicazione degli EM contribuisce a ripristinare condizioni di crescita sana, rigogliosa, pura e fertile.

Applicazioni pratiche dei Microrganismi Effettivi Nell'agricoltura:
I nostri EM migliorano significativamente il terreno permettendo:
- Incremento della fertilità del suolo e della biodisponibilità dei nutrienti.
- Riduzione dell'incidenza di malattie delle piante.
- Aumento della resa dei raccolti.
- Miglioramento della qualità nutrizionale dei prodotti.
Nella zootecnia
Gli EM apportano numerosi benefici:
- Miglioramento della salute di pelo, pelle e piumaggio.
- Aumento dell'assimilazione e della digeribilità del cibo.
- Incremento della fertilità e riduzione degli odori negli allevamenti.
- Diminuzione dell'uso di antibiotici e farmaci.
Nella vita quotidiana
I nostri prodotti a base di EM:
- Facilitano la pulizia e l'igiene domestica senza sostanze chimiche aggressive.
- Eliminano gli odori alla radice anziché mascherarli.
- Prevengono la formazione di muffe e biofilm.
- Rendono l'ambiente domestico più sano e bilanciato.
Per la salute umana
Gli EM contribuiscono al benessere attraverso:
- Stimolazione delle capacità di autoguarigione dell'organismo.
- Miglioramento della cicatrizzazione delle ferite.
- Supporto alla salute intestinale e al sistema immunitario.
- Ottimizzazione dei processi metabolici e digestivi.

Quali microrganismi compongono i nostri prodotti EM?
I nostri preparati contengono una combinazione bilanciata di:
- Lattobacilli: Proteggono l'intestino, aiutano la digestione e producono acido lattico che inibisce la crescita di patogeni.
- Batteri fotosintetici: Trasformano le sostanze organiche e l'energia solare in nutrienti utilizzabili da altri microrganismi e piante.
- Lieviti benefici: Producono sostanze bioattive come enzimi e vitamine, fondamentali per la crescita cellulare di piante e animali.
- Actinomiceti: Producono sostanze antimicrobiche che controllano i microrganismi patogeni e contribuiscono alla struttura del suolo.
- Altri microrganismi rigenerativi: Completano il consorzio microbico per un'azione sinergica ottimale.
La nostra formulazione esclusiva garantisce la stabilità e l'efficacia di questi microrganismi benefici, permettendo loro di lavorare in sinergia, per ripristinare l'equilibrio naturale in qualsiasi ambiente vengano applicati.